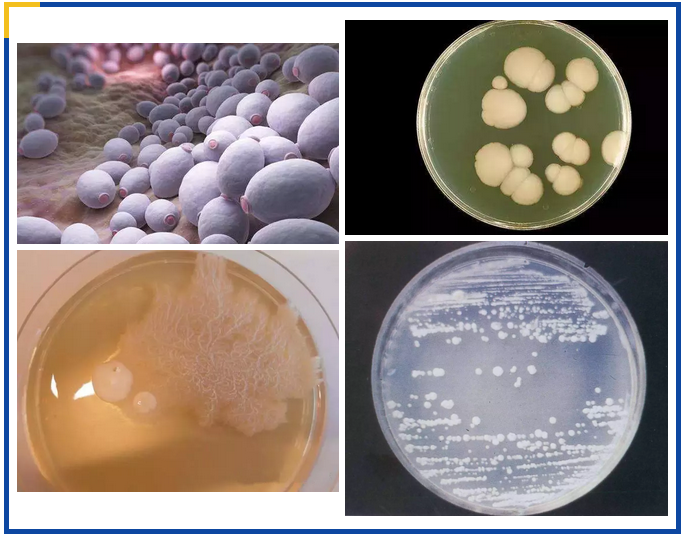

过度清洁消毒为什么会引起鹅口疮?
2019-05-09 09:49:42
鹅口疮是新生儿常见的口腔疾病,很多宝宝得了鹅口疮后,月嫂或者育儿嫂往往一脸茫然,搞不清究竟是哪个环节出了问题,这时家长多半会怪罪月嫂或者育儿嫂护理不当。但是月嫂或者育儿嫂觉得自己很冤枉,明明很仔细地进行了清洁工作,不仅奶瓶消毒很彻底,宝宝的衣物、家里的地板都严格地消毒清洁了,怎么还会得鹅口疮呢?
什么是鹅口疮?
鹅口疮是感染了一种叫做白色念珠菌的真菌引起的霉菌感染,口咽部白色念珠菌过度生长,就会形成白色乳凝块一样的小点或者小片状物,有时也会融合成大片。

如果用棉签轻轻擦拭孩子嘴里的白色斑膜,很容易被擦掉,且擦掉后粘膜光滑无损,则嘴里的是残余奶渍;相反,不容易擦掉还引起疼痛,擦掉后口腔粘膜红红的,就可以确认是鹅口疮了。
消毒过度反而会导致鹅口疮吗?

人类口腔中共有着超过700种细菌、真菌、病毒、螺旋体常驻,除了细菌之外,真菌也是口腔菌群的一员,与肠道菌群存在着密切的联系,也和人体健康休戚相关。它们在牙齿上、牙龈中、舌表面、唾液里独立存在,又互相依存。口腔菌群中有高达80种真菌,其中最主要的是念珠菌(candida)。在口腔菌群正常的情况下,念珠菌并没有什么存在感。

然而,如果正常口腔菌群遭到破坏时,例如为了追求所谓“无菌”、“消毒”而使用84拖地、用滴露洗衣服、用含有酒精的手消、湿巾擦手、喂奶前擦拭乳房等,这些杀菌剂都会留在这些物体表面,当孩子在地板上爬,舔地板,舔手,吃奶时,这些杀菌剂就会进入口腔,在没有建立正常的肠道菌群前,消毒剂就会把口腔里面的细菌、病毒杀灭,菌群的制衡被打破,念珠菌就会借机繁殖,此时的念珠菌通常会和其他坏细菌联手,一同作恶。例如,念珠菌会和变形链球菌一起造成龋齿;会和口腔链球菌(Streptococcus oralis )一起引发口腔黏膜的损伤,导致口咽部念珠菌病,也就是鹅口疮。

鹅口疮怎么治疗?



儿科医生田致洲表示,白色念珠菌不喜欢碱性,常用的治疗方法就是用1.4%的碳酸氢钠液清洁口腔。治疗的同时,宝宝所有能抓咬的地方和物品,都使用1%-4%的碳酸氢钠涂抹以消毒。个别严重的患儿,医生建议,使用治疗真菌的药物,比如制霉菌素等。10万单位/ml的制霉菌素溶液,用棉棒蘸溶液,涂抹宝宝口腔里面所有有白点的地方。每次大约使用2ml左右,每天使用3次,直到口腔内完全没有白点,再巩固2-3天左右,总共大约10天左右,这是因为白膜是真菌堆积形成的,肉眼看不见不代表真菌被消除了。

母乳喂养的妈妈,建议也使用制霉菌素涂抹乳房。
如果经过以上处理,鹅口疮仍然不愈,建议去医院就诊。

出现鹅口疮,家里怎么消毒?
白色念珠菌对于热的抵抗力不强,60摄氏度,加热1小时会杀灭。对干燥、阳光、紫外线、酒精等抵抗力较强。
所以,能煮的玩具、奶瓶、安抚奶嘴,就煮吧,煮完晾干。每次喂完奶后,使用制霉菌素涂抹妈妈的奶头,也要每日3-4次左右。妈妈的内衣,也要使用高温烫洗的方式清洗。

以上做好,基本就够了,其他地方无需使用制霉菌素涂抹,如果实在不放心,可以使用5%碳酸氢钠(也就是小苏打水)消消毒,多数有些效果。








